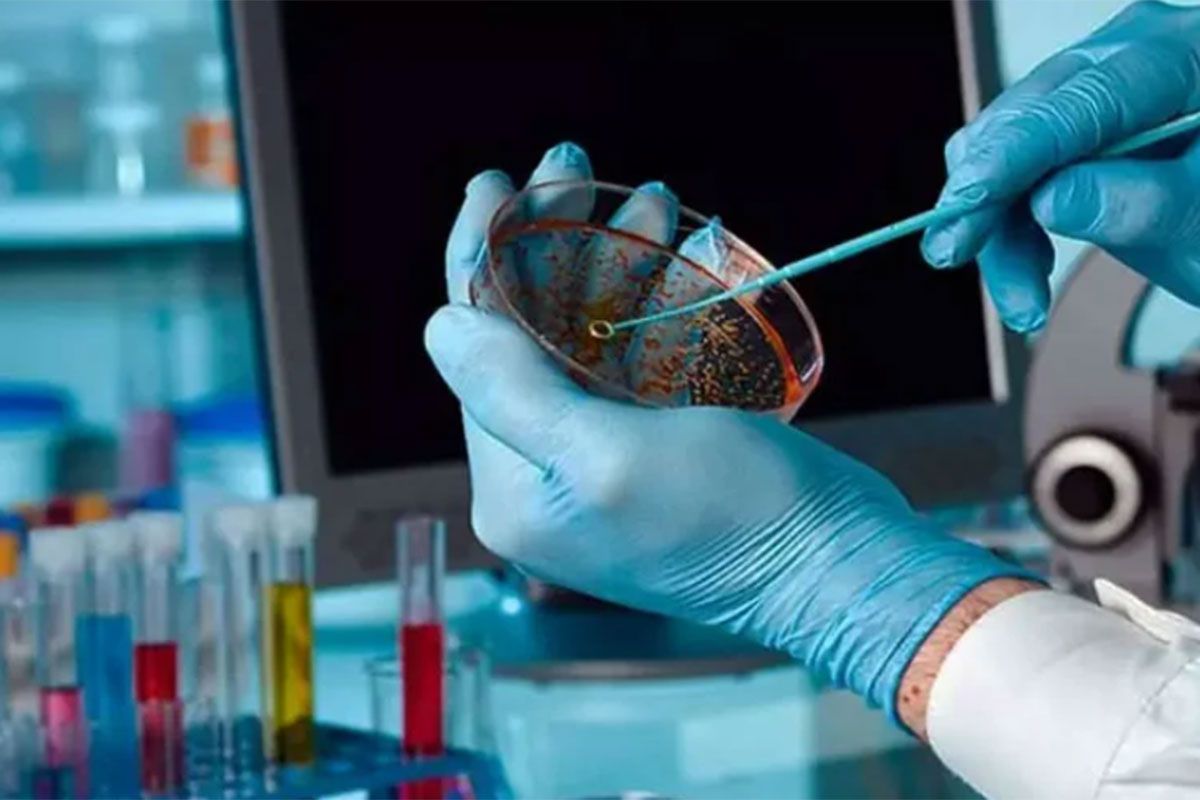

El doctor Martín López Vidal, investigador argentino en el Instituto Weizmann de Israel, lidera un estudio innovador que busca alterar artificialmente las funciones de proteínas para desarrollar tratamientos más efectivos y con menos efectos adversos. En una entrevista con Infobae, López Vidal compartió los detalles de este avance.
La biomedicina sigue avanzando a pasos agigantados en la búsqueda de soluciones para enfermedades complejas. El cáncer y las infecciones resistentes a los antibióticos son dos de los desafíos más formidables de la medicina moderna, y en este contexto, una investigación emergente está explorando cómo manipular proteínas para ofrecer enfoques terapéuticos alternativos. Aunque aún en etapas tempranas, este estudio sugiere la posibilidad de desarrollar terapias más dirigidas, abriendo la puerta a futuras innovaciones en el tratamiento de estas condiciones difíciles.
Uno de los principales investigadores detrás de esta prometedora investigación es Martín López Vidal, un joven científico argentino que forma parte del laboratorio del profesor David Margulies en el Instituto Weizmann de Ciencias de Israel, bajo una beca postdoctoral Ralph W. Hahn. Nacido en la ciudad de Córdoba, su trayectoria se forjó en las aulas de la Universidad Nacional de su provincia, donde comenzó su carrera como bioquímico. Allí también obtuvo su doctorado en Ciencias Químicas, pero su deseo de explorar nuevos horizontes del conocimiento y, por qué no, de la geografía, lo llevó a buscar oportunidades fuera del país. Experiencias en Austria, España y Canadá fueron sus primeras incursiones internacionales, donde cultivó una visión global de la ciencia y descubrió el poder transformador de la colaboración interdisciplinaria.
Hace ocho meses, dio un paso decisivo hacia un nuevo destino: Israel, el país que hoy se ha convertido en su hogar y centro de sus tareas de investigador. Allí se encuentra inmerso en este proyecto innovador que busca desarrollar terapias médicas más efectivas para el tratamiento de enfermedades como el cáncer y las infecciones resistentes a los antibióticos.
“Es un lugar hermoso, con gente apasionada y muy agradable”, dijo a Infobae el joven científico de 34 años, al describir este nuevo capítulo en su vida profesional y también familiar. Vive en la ciudad de Rehovot, al sur de Tel Aviv, junto a su esposa, psicóloga oriunda de Misiones, y trabaja en un entorno altamente colaborativo.
Su investigación se centra en la comunicación sintética entre proteínas y la activación artificial de enzimas, dos procesos biológicos que, si se manipulan correctamente, tienen el potencial de ofrecer terapias mucho más específicas y efectivas. En lugar de depender de tratamientos generales, estas terapias apuntan a corregir los desequilibrios moleculares de manera más precisa, lo que podría llevar a nuevos enfoques menos invasivos y más dirigidos.
La comunicación entre proteínas es un concepto central en su investigación. Según explicó López Vidal durante la entrevista con Infobae, en el marco de una breve visita que realizó al país, las proteínas son “estructuras esenciales que forman parte de los sistemas vivos” y desempeñan funciones estructurales o regulatorias que permiten que los organismos realicen sus funciones vitales. En biología, algunas proteínas interactúan entre sí para activar o desactivar ciertas funciones dentro de las células. Sin embargo, muchas veces hay proteínas que, aunque deberían comunicarse, no lo hacen. “Es como si dos cosas no tuvieran ninguna relación entre sí, pero al forzar su interacción, logramos que una actúe sobre la otra”, explicó. El equipo científico en el Weizmann está trabajando en técnicas para forzar esta comunicación entre proteínas que no se conectan naturalmente, lo que les permitiría corregir desequilibrios en enfermedades.
La activación artificial de enzimas, definidas como proteínas que catalizan reacciones químicas en las células, se lleva a cabo mediante la introducción de una molécula externa diseñada en el laboratorio. “Decimos que es artificial porque es a partir de algo que agregamos, algo que sintetizamos nosotros”, señaló. Esta intervención tiene como objetivo lograr que enzimas que de otro modo no se comunicarían entre sí puedan interactuar de manera controlada. El resultado podría ser el desarrollo de tratamientos innovadores, tanto para infecciones bacterianas como para el cáncer.
Por ejemplo, en el caso de las infecciones resistentes a los antibióticos, López Vidal recordó que una de las grandes preocupaciones actuales es la resistencia antimicrobiana, que hace que bacterias como Staphylococcus aureus, resistente a la meticilina, sean cada vez más difíciles de tratar. En este contexto, la comunicación artificial de proteínas podría ofrecer una vía para reclutar al sistema inmune hacia el sitio de la infección, mejorando la respuesta del cuerpo y ayudando a eliminar la bacteria sin depender exclusivamente de antibióticos.
“Lo bueno de estas terapias alternativas es que serían libres de antibióticos, por lo cual el problema de la multirresistencia no sería tan grande, y además, podríamos complementarlas con los antibióticos convencionales”, explicó. Así, este enfoque no reemplazaría a los tratamientos actuales, pero los reforzaría aumentando la eficacia del tratamiento convencional.
En cuanto al cáncer, las células tumorales “muchas veces expresan mucho de una proteína que las ayuda a sobrevivir o expresan muy poca de una que les disminuye la supervivencia. Es como un mecanismo que tienen las células tumorales de sobrevivir o de romper este desbalance entre supervivencia y muerte y proliferar”. El desafío de los tratamientos actuales es encontrar una forma específica de atacar estas células sin afectar al resto del cuerpo. López Vidal y su equipo buscan localizar las proteínas sobreexpresadas en las células tumorales para luego manipular estas interacciones y comunicar estas proteínas con otras que puedan ejercer un efecto terapéutico cercano a la célula cancerígena. Este proceso tendría como objetivo atacar el sistema inmune para que intervenga de manera más efectiva. El investigador subrayó que podría especializarse en ciertos tipos de cáncer, como el de mama o próstata, al atacar proteínas específicas presentes en esas células tumorales.
De este modo, la capacidad de activar enzimas que promueven la muerte celular programada únicamente dentro de células tumorales podría revolucionar los regímenes de tratamiento, haciendo posibles las terapias que minimicen el daño a tejidos sanos. Del mismo modo, en infecciones resistentes a antibióticos, el uso de enzimas modificadas para desactivar mecanismos de resistencia bacteriana específicos podría rejuvenecer la eficacia de los antibióticos existentes.
El desafío técnico que enfrenta este tipo de investigaciones radica en el diseño de moléculas capaces de conectar de manera precisa las proteínas involucradas. “El problema es que estas moléculas son grandes y puede ser difícil crearlas”, comentó López Vidal. Sin embargo, su objetivo no es crear el fármaco perfecto de inmediato, sino establecer principios que guíen la creación de versiones más eficientes en el futuro. Aunque la investigación está en una etapa temprana, ya existen publicaciones que respaldan el concepto de comunicación artificial entre proteínas, lo que demuestra el potencial de esta tecnología.
Según el estudio, que lleva la firma del doctor Margulies y otros colegas de López Vidal en el laboratorio israelí, la posibilidad de activar o desactivar enzimas de manera controlada mediante iones de calcio no solo permite una precisión sin precedentes en la modulación de la actividad enzimática, sino que también sugiere una aplicación potencial para el desarrollo de terapias dirigidas que podrían ser activadas en el sitio específico de la enfermedad, reduciendo los efectos secundarios asociados con los tratamientos más generalizados.
El científico argentino destacó que se trata de una línea de investigación prometedora para el futuro de la medicina y resaltó la importancia de la interdisciplinariedad en la ciencia. El trabajo en el Instituto Weizmann permite a los científicos colaborar con expertos de diversas áreas, como biólogos, químicos, inmunólogos y bioquímicos, lo que hace que los proyectos sean más completos y abarcativos, dijo.
“Esto permite que estos proyectos, que pueden ser muy locos, puedan llevarse a cabo con la ayuda de expertos en diferentes áreas”, explicó. La combinación de conocimientos de distintas disciplinas abre nuevas posibilidades para tratamientos más específicos y efectivos y lleva a la ciencia básica hacia aplicaciones terapéuticas con un potencial considerable para cambiar la medicina tal como la conocemos hoy.